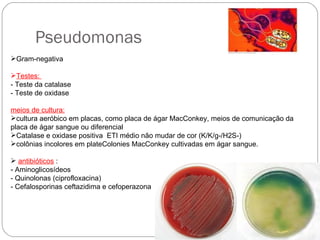
Pseudomonas Gram-negativa Testes:  - Teste da catalase  - Teste de oxidase  meios de cultura: cultura aeróbico em placas, como placa de ágar MacConkey, meios de comunicação da placa de ágar sangue ou diferencial Catalase e oxidase positiva  ETI médio não mudar de cor (K/K/g-/H2S-)  colônias incolores em plateColonies MacConkey cultivadas em ágar sangue. antibióticos  :  - Aminoglicosídeos  - Quinolonas (ciprofloxacina)  - Cefalosporinas ceftazidima e cefoperazona

Sepse ou septicemia é uma condição em que bactérias se multiplicam rapidamente no sangue, podendo causar choque séptico e risco de morte. Pode ser causada por bactérias gram-positivas como Staphylococcus aureus ou gram-negativas como Pseudomonas e Enterobacteriaceae. O diagnóstico é feito por exames de sangue e tratamento envolve antibióticos de amplo espectro e medidas de suporte para manter a pressão sanguínea.